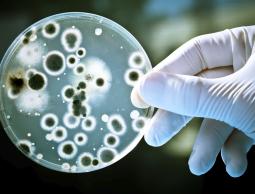
صورة تعبيرية

شقت صناعة إعادة تدوير النفايات البلاستيكية طريقها إلى قطاع غزة في محاولة جديدة للتغلب على الحصار المفروض على القطاع منذ أكثر من عقد، وذلك في صناعة فلسطينية بامتياز بدءًا من المواد القديمة التي تجمع من القمامة، وحتى آلات التي صنعت بعقول غزية لتعويض غياب استيراد الآلات المتخصصة في هذا المجال.
وتقوم صناعة إعادة التدوير على جمع مخلفات البلاستيك من الشوارع، وبيعها لأحد مصانع البلاستيك في القطاع لإعادة تدويرها، حيث تخرج إلينا من جديد قطع بلاستيكية بإمكانيات وجودة مرتفعة إلى حد ما.
وحسب احصائيات سابقة فإن قطاع غزة ينتج 1900 طنّ من النفايات الصلبة يوميّاً، منها ما نسبته 35 % نفايات بلاستيكيّة وورقيّة وزجاجيّة، لذلك كان من المجدي والمهم التفكير بإعادة تدويرها في مساهمة بيئية ومحاولة للاكتفاء الذاتي، وتقول بعض الاحصائيات غير الرسمية إن احتياجات قطاع غزة أقل من النفايات البلاستيكية المتوفرة.
ولكن وحسب لقاء الرسالة مع المهندس خليل الرملاوي مدير العلاقات العامة والجودة في مصنع الرملاوي للبلاستيك، فإن أبرز معوقات صناعة إعادة التدوير تتمثل في عجز الكهرباء وعدم إدخال آليات حديثة لقطاع غزة بسبب الحصار المفروض عليه، بالإضافة إلى عدم توفر الدعم الحكومي للأفكار والمصانع التي تقوم على أفكار محلية، مضيفاً أن "المصنع حتى الآن يعمل بنصف الطاقة"، مبيناً أن هذه الأسباب تقف عائقاً أمام الصناعات البلاستيكية بوجه عام.
وهذه المهمة تعد حلا جيدا في الفترة الحالية لمشكلة النفايات الصلبة للاستفادة منها قدر الإمكان، والتغلب على غياب المواد الخام التي تدخل في صناعة البلاستيك.
يقول الرملاوي إن المصنع تم إنشاؤه في عام 1986 وقد بدأ في صناعة النايلون منذ نشأته وحتى الآن بالإضافة إلى خراطيم المياه، ويضيف: "وقد حصلنا في سنة 2007 على شهادة الجودة الفلسطينية، ومنذ ذلك التاريخ بدأنا في خوض تجربة إعادة التدوير، لأنه وفي هذا العام أيضا منع الاحتلال دخول المواد الخام التي تدخل في صناعة البلاستيك، ورغم أن الاحتلال سمح بعد ذلك بسنوات بدخول المواد الخام لفترة محدودة إلا أن المنع عاد مرة أخرى منذ بداية أغسطس من هذا العام، فاضطرنا ذلك للعودة إلى فكرة إعادة التدوير".
عن طريقة إعادة التدوير يقول المهندس خليل للرسالة: بدأنا إعادة التدوير بأمور بسيطة وتجارب كبيرة جدا أوصلتنا في البداية لطريق مسدود لأن النتيجة لم تكن بالجودة المطلوبة كما كنا نصنع بالمواد الأصلية الخام، وبعدها لجأنا إلى البحث عن طريق الانترنت وقمنا بعمل دراسة متكاملة وذهبنا إلى مصر للاستفادة من التجارب بهذا المجال وعرضنا المشروع على أكثر من مؤسسة حتى أصبح لدينا خبرات وقدرات على تصنيع آلات بدائية محلية بالاستعانة بمهندسين لصناعتها وتصميمها وفعلاً نجحت التجربة إلى حد كبير".
ثم تطور العمل حينما سمح لنا الاحتلال باستيراد آلات حديثة في عام 2012 فأصبح الإنتاج أفضل بكثير.
ويشرح الرملاوي للرسالة المراحل التي تمر فيها المخلفات البلاستكية منذ شرائها من باعة ومتجولين امتهنوا جمع النفايات البلاستيكية وبيعها للمصانع بهدف إعادة التدوير، حيث يقول: "يمر البلاستيك أولاً بعملية الجرش عن طريق الآلات الموجودة خصيصا لهذه العملية، ومن ثم يتجه إلى عملية الغسيل، حيث يوضع في أحواض بلاستيكية مصنوعة محليًا، وهي أشبه بالغسالة، يدور فيها البلاستيك المجروش في عملية تنظيف لأكثر من مرة قبل أن ينتقل إلى مرحلة التنشيف وهي عملية مهمة، لأن نسبة الرطوبة في البلاستيك الجاهز للاستخدام يجب ألا تتخطى 1%، وبعدها يتم تشكيلها على شكل حبيبات بلاستيكية تتعرض للتبريد لمدة 24 ساعة حتى تكون جاهزة للاستخدام والتشكيل".
وقد عرض علينا الرملاوي بعضًا من إنتاج المصنع، موضحا الفروقات التي يمكن أن تكون بين المنتج المعاد تدويره والمنتج المصنوع من المواد الأصلية الخام، مشددًا على أهمية عدم استخدام البلاستيك المعاد تدويره في الاستخدامات الأدمية، كتغليف الطعام مثلا.
وتعليقاً على الموضوع التقينا سامي النفار رئيس اتحاد الصناعات الوطنية، والذي قال للرسالة، إن عدد المصانع المسجلة لديهم يصل إلى 75 مصنعًا منها 70% يعمل في مجال إعادة التدوير، ولا يوجد رقم واضح بهذا الخصوص لأن الأرقام مرهونة بحالة دخول المواد الخام والحصار، فإذا منعت المواد الخام يزداد الطلب على "المجروش" والذي يقصد به البلاستيك المعاد تدويره.
ويضيف: "إعادة التدوير شيء مهم وعملية جيدة لأنها تخدم البيئة وتستغل النفايات استغلالًا إيجابيًا، ولكن هناك شروط لإعادة تصنيعه، فهو لا يستخدم مطلقاً للاستعمال الآدمي إنما يستخدم في الأغلب في شبكات الصرف الصحي والري، والاستخدامات الكهربائية، ونحن لدينا قوانين صارمة بهذا الخصوص لأن فيها نوعا من السمية، ولكنها فكرة جيدة لخدمة البيئة لأن النفايات البلاستيكية معروفة بأنها لا تذوب، وهذا يساهم في التخلص منها".